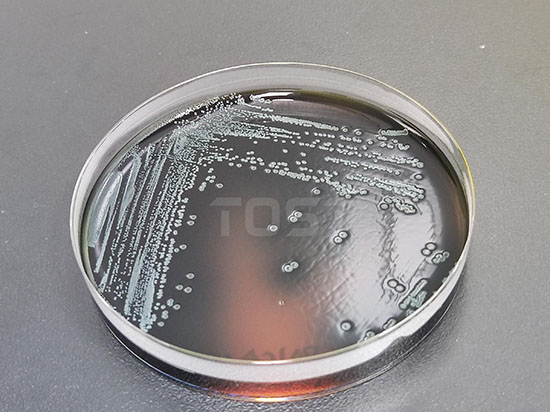
484558fd12c27753129ce1680a53fceb.jpg

不少人认为把吃不完的食物放进冰箱就万事大吉了,甚至将食材放冰箱中很长时间仍食用。
我们实验室在多次检测食品微生物中发现:冰箱只是“延缓变质进程”,无法“阻断微生物活动”。

图片来源千图网
即便处于低温环境,微生物依然活跃。耐冷细菌一样会缓慢繁殖,超长时间储存的食物不仅会出现明显的营养流失,还可能会因细菌超标引起的肠胃不适。
作为专业的第三方检测机构,我们从科学检测角度,拆解冰箱储存的常见误区与安全准则。
冰箱冷藏层温度稳定在 4℃±2℃,冷冻层温度低于 -18℃。其核心功能并非杀菌,而是降低微生物代谢速率,以此有效延长食物保鲜时长,使食材能更长久地保持新鲜状态。实验室检测数据显示,家庭冰箱中存在多种耐低温致病菌,其活性远超公众认知:
李斯特菌,堪称“冰箱致病菌之王”。即便置身4℃的低温之境,仍能缓慢繁衍。只需短短几日,就可能累积到致病剂量,其潜在危害着实不可小觑。
冷冻层中的细菌,即便冷冻环境能使其陷入休眠状态,但其细胞壁没有破坏,一样具有潜在的活性与威胁。我们做过冷冻猪肉循环实验:将猪肉解冻后放置一段时间(细菌开始繁殖),再冷冻数天,再次解冻后,沙门氏菌检出量大幅升高 —— 反复解冻相当于给细菌 “多次繁殖机会”。

图片来源千图网
实验室通过分析近百起食品污染案例发现,多数家庭存在以下储存误区,会直接加速食物变质与细菌污染:
生肉、生海鲜表面携带的沙门氏菌、副溶血性弧菌(生海鲜常见菌),易通过汁水渗漏、包装摩擦等污染熟食。

图片来源千图网
我们的模拟实验显示:将生鸡肉(含沙门氏菌)与凉拌黄瓜放在同一层,24 小时后黄瓜就可能被沙门氏菌污染;若生肉未密封,汁水滴落到下层的面包上,面包的污染风险会显著增加。
未密封的食物不仅会 “串味”,更会吸收冰箱内的潮气与浮游细菌。对冰箱内不密封保存摆放的剩菜进行检测后,结果如下:
裸放的馒头,在短短48小时内,其表面便极易滋生霉菌。与之相较,密封存放的馒头,霉菌滋生的风险则大幅降低,远不及裸放馒头容易受霉菌污染。

图片来源千图网
更关键的是,部分细菌繁殖时会产生耐热毒素。后续即便经过加热,毒素也难以被破坏。人体若摄入含此毒素的物质,仍可能出现呕吐、腹泻等不适状况,需格外留意。
我们对冷冻猪肉进行 “解冻 - 冷冻” 循环测试(每次解冻至常温一段时间,再冷冻数天),结果显示:
• 第一次循环后,细菌总数就会明显增加;
• 多次循环后,菌落总数会大幅升高,且沙门氏菌检出量会大幅超标。
解冻之际,细菌自休眠中苏醒,迅速繁衍。再次冷冻不过是令其活动暂停,已繁殖的细菌很难清除。待下次解冻,细菌便会以更迅猛之势快速繁殖。
我们结合食品特性与微生物繁殖规律,整理出各类食物的冰箱安全储存周期,超过此时间,即便外观无异常,也不建议食用:

经实验验证,我们总结出三种储存方法,可大幅降低冰箱食物的变质率。此三种方法能够有效降低污染风险,具有显著的实用价值。
生肉、生海鲜需用带锁扣的密封盒装好,放置在冰箱最下层(避免汁水渗漏污染上层食物),盒底可垫吸水纸吸收冷凝水;

图片来源千图网
上层宜放置熟菜、水果与即食食品,建议采用透明密封盒盛装。这样既能保障食品存放,又便于随时观察其新鲜度。
运用“下层生、上层熟、全密封”的储存模式,能有效规避食物间的相互干扰,显著降低食物交叉污染的机率,保障食材的卫生与安全。
新购食材宜放于冰箱内侧,先前存放的放于外侧。规律放置可有效规避旧食材遭遗忘的情况,让食材管理更为合理。
用标签记录食材存放日期(如 “生牛肉,2025.10.20”),尤其冷冻肉类,避免超期储存;
每周可进行一次 “冰箱盘点”,及时清理超过安全周期的食材,这样食物浪费情况会明显改善。
每周用稀释的含氯消毒剂,像 84 消毒液,仔细擦拭冰箱隔板与抽屉。此方法能高效杀灭冰箱表面细菌,对比清水擦拭,清洁效果更佳,能有效保障冰箱内部卫生。

图片来源千图网
每月清空冷冻层,解冻后彻底清洁,清除结冰(冰层过厚会影响制冷效率,导致局部温度升高,加速细菌繁殖);
若家中有老人、小孩或免疫力欠佳者,建议每季度委托第三方机构开展微生物检测,重点检测李斯特菌、沙门氏菌,以便及时排查潜在风险,保障家人健康。
食物安全储存的核心要义,在于精准“控制微生物繁殖”,有效“避免污染”。
双管齐下能确保食物在储存期间的品质与安全。
只要掌握科学的储存方法,遵循安全时间表,就能降低冰箱食物的安全风险。
记住:冰箱的作用是 “延长新鲜期”,而非 “无限期保鲜”,理性看待冰箱功能,守护餐桌安全。